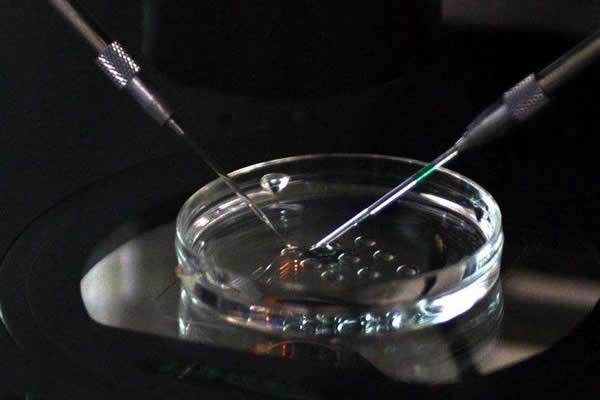

完整版本的做试管婴儿的流程,探秘胚胎宝宝的试管之旅!
- 试管婴儿
- 2024-01-17 09:30
做试管婴儿的流程是怎样的?试管婴儿又称体外受精-胚胎移植( IVF-ET),顾名思义试管宝宝与自然宝宝最大的区别是精子与卵子的受精过程是在体外完成的,而后受精卵在体外发育3~7天再进行胚胎移植送回母亲子宫内,之后胚胎在子宫内着床和发育的过程与自然宝宝一样。完整版本的做试管婴儿的流程看似简单,但是具体细划分下来,却分了很多的步骤。一个试管宝宝的诞生,就如同西天取经一般,要经历众多劫难,下面就让我们看看试管宝宝需要经历哪些“劫”难吧!
做试管婴儿的流程第一步:促排卵
正常情况下,女方在一个经期内卵巢会有多个卵泡同时发育,但最终只有其中一个能够发育成熟并被排出,等待精子的到来。然而在试管婴儿的精卵结合和受精卵发育过程中,会有一部分样品因受精、发育失败而废弃,所以为了提高试管婴儿的成功率,医生会安排女方使用一系列的促排卵药物,使一批卵泡同时发育,长大并且成熟。当然有一小部分女性因卵巢功能能特别不好导致没有一个成熟卵泡生成,从而使得试管宝宝在第一个“劫”面前有心无力,独自哀伤!
做试管婴儿的流程第二步:取卵取精
在卵子发育成熟后,医生会安排女方取卵,取卵是在手术室进行的,方式是在超声引导下,使用一根细长的穿刺针经过阴道穿刺取卵。 与此同时,男方需要在取精室通过手淫的方式排出精液交给实验室,也有少部分重度、极重度少弱精子症或无精子症的男性可以通过睾丸或附睾穿刺手术取出精子,前提是睾丸仍有生精功能。取卵和取精的过程看似简单。也有部分女性卵巢内卵泡看似成熟,但在实验室观察时却是不成熟卵,或是部分男性手淫取精失败让试管宝宝没有安然渡过这第二个“劫”。
做试管婴儿的流程第三步:体外授精
在实验室中,让卵子受精的方式有两种,这也是第一代和第二代试管婴儿唯一一个不同之处。第一代是
把处理后的卵子和精子放在同一个培养液中让其自然受精,此过程是最接近自然受孕的,也是最常用的。而第二代是将单个精子用显微注射器注射到卵子里,代替了精卵自然结合的过程,采用这种方式主要是因为男性患有重度、极重度少弱精子症或无精子症,通过手术取出的精子比较稀少,不容许像第一代
“竞争上岗”的方式让其自然受精。一般情况下,第一代和第二代有60%~80%的卵子可以正常受精,当然如果运气实在不好,所有的卵子都遇到另20%~40%的概率也是有可能的。
做试管婴儿的流程第四步:胚胎培养和移植
一般正常受精的受精卵会在受精后第3 天明裂成8细胞的胚胎,这个过程称为卵裂期。第4天胚胎发育到桑棋胚阶段。到了第5天胚胎发育到囊胚阶段,在大部分情况下只有最强壮的胚胎才能发育到第5天形成囊胚,这也是不少女性虽然取卵很多,但最终可移植的胚胎寥寥无几的原因。胚胎自身会有优胜劣汰的过程,精子畸形、染色体异常等都会影响到胚胎发育。通常我们会选择第3天卵裂期的胚胎或第5~6天囊胚期的囊胚进行移植,这种情况我们称之为新鲜胚胎移植。如果女方因为促排卵过程导致卵巢过度刺激,或是子宫内膜厚度及形态不适宜胚胎着床,我们会将胚胎冷藏起来,待女方子宫适宜妊娠的时候再进行解冻胚胎移植。
做试管婴儿的流程第五步:胚胎着床、生长发育、出生
如果把前面的几个“劫”当作是试管宝宝的一道道门槛,那么第五劫就是一座大山, 许多不孕不育夫妇都在这座大山面前止步。胚胎能不能安全着陆到子宫上受许多因素的影响,比如胚胎本身质量、子宫内环境、免疫因素以及女方精神状态等等。在这个过程中需要使用一系列的药物支持胚胎的发育,直
至胚胎正常着床。接下来就与自然孕期一样,做好保胎和产检,等待正常分娩,迎接小生命的诞临。
随着试管婴儿技术的迅猛发展,全国大大小小的生殖中心越来越多,通过中华医学会生殖医学分会的数据上报系统,得到2014- -2016 三年间全国平均的新鲜胚胎移植活产率约为42%,解冻胚胎移植活产率约为40%。
总结:以上就是做试管婴儿的五大步骤流程,看到这里,相信大家都已经了解清楚了试管宝宝是怎样从无到有的了。在每一个步骤流程中,都可能会遇到这样和那样的问题,任何一个环节的差错都有可能导致周期的失败而不得不重头再来。试管婴儿并不是一蹴而就的,希望通过医生的帮助,和您的积极配合,为您带来“好孕”。

发表评论